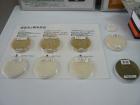

若旦那の広島びいき - 中国醸造さんの工場見学!
ヘッダーナビゲーション
中国醸造さんの工場見学!2009/12/16 2:00 pm
さて、中国醸造さんの工場見学の続きです。
本社の受付前に案内いただきました。

中国醸造さんでは毎年モンドセレクションに積極的に
挑戦されておられます。
最高金賞を含めて数々の賞を受賞されておられます。

この写真わかりますか?
南極探検隊の写真ですが、右側にみえるのは、、
そう!
中国醸造さんの日本酒です!
日本で始めて南極に渡った日本酒なんです!
凄い技術力ですね!
無菌充填で日本酒の風味をそのまま維持できるパック酒なので、
軽量で品質保持期間が格段に長く、採用されたのだそうです。

純米、大吟醸、など日本酒にはいろんな種類がありますが、
その種類は米の削り方などによるそうです。
なんと65%も削られる酒もあるんですって!

続いて、アルコールの蒸留塔

にお邪魔しました。


めちゃくちゃ大きな設備です。
さとうきびから精製されたアルコールをこの蒸留塔で
純度の高いアルコールにするんだそうです。
そして、この大きな機械は

フランス製でした!!!!


壊れたらどうするんでしょうか!
といらない心配をしてしまいました
それでは撮影してきた動画で、迫力を味わってください!
瓶をケースにつめています。
瓶を洗浄しています。
充填後にチェックしています!
洗浄されたビンがどんどん進んでいきます。
一升瓶に充填されていきます。
蓋をしめています。
パック酒が充填されています。
ラベルを貼って、ケースにつめています。
本社の受付前に案内いただきました。
中国醸造さんでは毎年モンドセレクションに積極的に
挑戦されておられます。
最高金賞を含めて数々の賞を受賞されておられます。


この写真わかりますか?
南極探検隊の写真ですが、右側にみえるのは、、
そう!
中国醸造さんの日本酒です!
日本で始めて南極に渡った日本酒なんです!
凄い技術力ですね!
無菌充填で日本酒の風味をそのまま維持できるパック酒なので、
軽量で品質保持期間が格段に長く、採用されたのだそうです。
純米、大吟醸、など日本酒にはいろんな種類がありますが、
その種類は米の削り方などによるそうです。
なんと65%も削られる酒もあるんですって!
続いて、アルコールの蒸留塔
にお邪魔しました。
めちゃくちゃ大きな設備です。
さとうきびから精製されたアルコールをこの蒸留塔で
純度の高いアルコールにするんだそうです。
そして、この大きな機械は

フランス製でした!!!!



壊れたらどうするんでしょうか!
といらない心配をしてしまいました

それでは撮影してきた動画で、迫力を味わってください!
瓶をケースにつめています。
瓶を洗浄しています。
充填後にチェックしています!
洗浄されたビンがどんどん進んでいきます。
一升瓶に充填されていきます。
蓋をしめています。
パック酒が充填されています。
ラベルを貼って、ケースにつめています。








